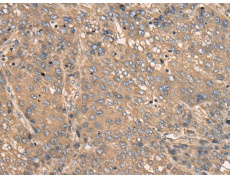
一抗

中文名稱:兔抗C2CD2多克隆抗體
|
Background: |
C2CD2 is an 696 amino acid protien that is secreted. The C2CD2 gene product has been provisionally designated C2CD2 pending further characterization. |
|
Applications: |
ELISA, IHC |
|
Name of antibody: |
C2CD2 |
|
Immunogen: |
Fusion protein of human C2CD2 |
|
Full name: |
C2 calcium-dependent domain containing 2 |
|
Synonyms: |
TMEM24L; C21orf25; C21orf258 |
|
SwissProt: |
Q9Y426 |
|
ELISA Recommended dilution: |
5000-10000 |
|
IHC positive control: |
Human liver cancer |
|
IHC Recommend dilution: |
25-100 |

 購物車
購物車 幫助
幫助
 021-54845833/15800441009
021-54845833/15800441009